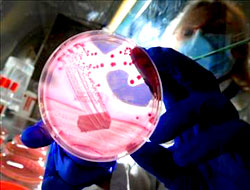
Ölümcül bakterinin yeni adresi!

Almanya'da ortaya çıktıktan sonra özellikle Avrupa ülkelerinde hızla yayılan ve şimdiye kadar 23 kişinin ölümüne yol açan ölümcül EHEC bakterisi Kanada'da da görüldü.
Ontario Eyalet Sağlık Şefi Dr. Arlene King, Toronto'nun batısındaki Peel kenti sakinlerinden olan ve bir süre önce Almanya'ya gidip geldiği belirlenen yetişkin bir erkekde EHEC bakterisi saptandığını açıkladı.
Hastanın Almanya'da olduğu sürede, salgının en etkili olduğu bölgede salata ve yeşil sebze tükettiğini kaydeden Dr. King, kesin tanı için hasta üzerinde bir dizi test başlatıldığını söyledi. Hastanın hastaneye yatırılmadığını ancak kendileri ile sürekli temas halinde olacağını ifade eden Dr. Arlene King, tedaviye de eşzamanlı başladıklarını kaydetti.
Öte yandan Kanada Gıda Denetim Ajansı ekipleri, ülkeye dışarıdan gelen domates, salatalık ve marul başta olmak üzere yeşil sebzelerde yapılan denetimleri yoğunlaştırdı. Sağlık ekipleri de, dünya genelinde şu ana kadar en az 2500 kişinin enfekte olması nedeniyle Almanya'dan gelenleri havaalanı ve gümrüklerde kontrolden geçiriyor.

ve büyük harflerle yazılmış yorumlar onaylanmamaktadır.